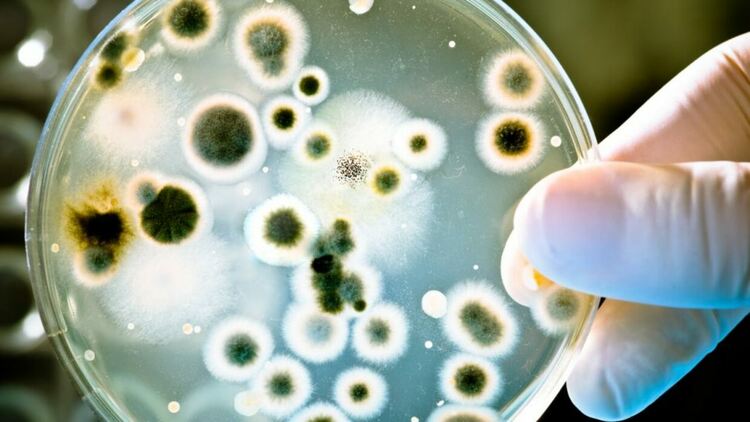
Чрез микропластмасата се разпространяват опасни бактерии

Освен че са вредни сами по себе си, микропластмасите могат да носят още по-сериозни рискове, откриват наскоро специалисти. Една от причините е, че върху тези малки пластмасови частици се образуват тънки слоеве микроби, наречени биофилми или „пластисфери“. Според учените този слой може да съдържа опасни бактерии и да им помага да оцеляват по-дълго.
Това означава, че микропластмасите не само замърсяват околната среда, но и могат да разпространяват болестотворни микроби и бактерии, устойчиви на лекарства. Такива бактерии са трудни за лечение и могат да направят много медицински процедури по-рискови.
В новото изследване по темата се казва, че „микропластмасата може да действа като носител на вредни патогени, като подпомага тяхното оцеляване и разпространение“. Резултатите от изследването са публикувани в сп. Environment International.
Освен това вече се знае, че микропластмасите лесно абсорбират други токсични замърсители, което допълнително увеличава опасността. Така малките пластмасови фрагменти могат да се превърнат в преносители на множество вредни вещества и микроби.
За да изследват проблема, учените са поставили нишки от малки пластмасови пелети (използвани в производството и пречистването на водата), както и дребни парчета полистирен на различни места по реката Труро в югозападна Англия. Те избрали участъци с различна чистота на водата, включително райони близо до пречиствателна станция и болница.
След два месеца изследователите проверили какви бактерии са се натрупали върху частиците. Оказало се, че върху тях се развивали много гени, свързани с антибиотична резистентност.
Освен това върху микропластмасата били открити вредни бактерии като Flavobacteriia и Sphingobacteriia, особено на места по течението след болница и пречиствателна станция. Интересното е, че тези бактерии не били толкова разпространени във водата сама по себе си, което означава, че пластмасовите фрагменти ги привличат или подпомагат растежа им.
Flavobacteriia и Sphingobacteriia са групи бактерии, които обикновено се срещат във вода и почва, но някои техни представители могат да бъдат вредни.
Flavobacteriia често се свързват със заболявания по риби и други водни организми. Този вид бактерии могат да причинят инфекции, които водят до кожни рани, затруднено дишане и висока смъртност при рибите. Някои видове от тази група могат да предизвикат инфекции и при хора с отслабена имунна система.
Sphingobacteriia също са често срещани в околната среда и могат да се прикрепят към различни повърхности, включително пластмаса. Някои от тези бактерии показват устойчивост към антибиотици и са способни да причинят инфекции при хора, особено в болнични условия, където пациентите са по-уязвими. Тези инфекции може да засегнат кожата, белите дробове или кръвта, но най-често се срещат при хора с отслабена имунна система.
И двете групи бактерии стават по-опасни, когато се натрупват върху микропластмаса, защото пластмасата им помага да оцеляват по-дълго, да се пренасят по-далеч в реките и морето и евентуално да достигнат до животни или хора, които иначе не биха били изложени на тях.
Така че микропластмасата не е само проблем за природата, а може и да участва в разпространението на бактериална резистентност към лекарства при нас, хората.
Референции:
1. Stevenson, Emily M., et al. „Sewers to Seas: Exploring Pathogens and Antimicrobial Resistance on Microplastics from Hospital Wastewater to Marine Environments.” Environment International, 20 Nov. 2025, p. 109944, www.sciencedirect.com/science/article/pii/S0160412025006956, https://doi.org/10.1016/j.envint.2025.109944.
2. Thompson, Richard C., et al. „Twenty Years of Microplastics Pollution Research—What Have We Learned?” Science, vol. 386, no. 6720, 19 Sept. 2024, https://doi.org/10.1126/science.adl2746.